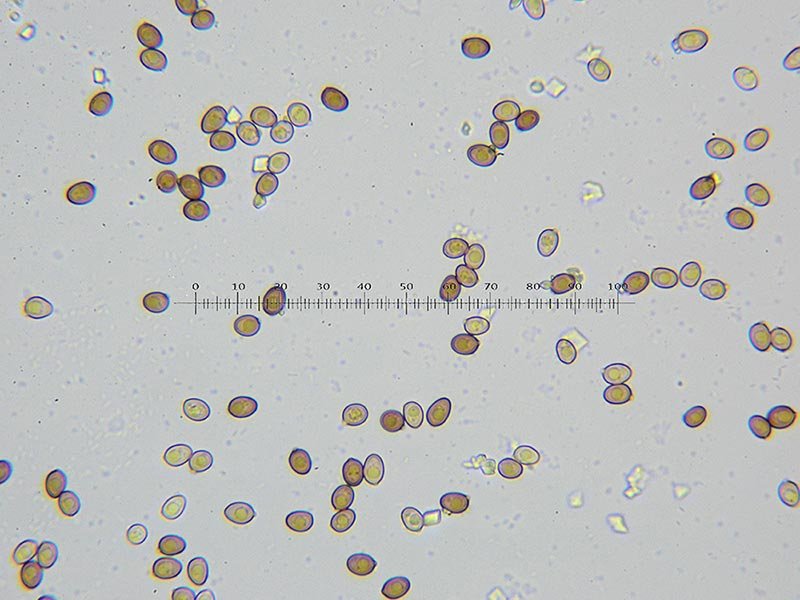

-
Numero contenuti
9972 -
Iscritto
-
Ultima visita
Tipo di contenuto
Profili
Forum
Orchidee
Diventa Socio
Calendario
Tutti i contenuti di Felice Di Palma
-

2019.11 - Lazio - Tutor Tomaso Lezzi
Felice Di Palma ha risposto alla discussione di Tomaso Lezzi in Funghi Trovati Anno 2019
-

2019.11 - Lazio - Tutor Tomaso Lezzi
Felice Di Palma ha risposto alla discussione di Tomaso Lezzi in Funghi Trovati Anno 2019
Lepiota ignivolvata Bousset & Josserand; Regione Lazio; Tenuta di Castelporziano, Novembre 2019; Foto di Felice Di Palma. -

2019.11 - Lazio - Tutor Tomaso Lezzi
Felice Di Palma ha risposto alla discussione di Tomaso Lezzi in Funghi Trovati Anno 2019
Amanita gracilior Bas & Honrubia; Regione Lazio, Roma, Tenuta di Castelporziano; Novembre 2019; Foto di Felice Di Palma. -

2019.11 - Lazio - Tutor Tomaso Lezzi
Felice Di Palma ha risposto alla discussione di Tomaso Lezzi in Funghi Trovati Anno 2019
Amanita phalloides (Vaill. ex Fr. : Fr.) Link; Regione Lazio, Tenuta di Castelporziano; Novembre 2019; Foto di Felice Di Palma. La varietà alba. -

2019.11 - Lazio - Tutor Tomaso Lezzi
Felice Di Palma ha risposto alla discussione di Tomaso Lezzi in Funghi Trovati Anno 2019
Lepiota aspera (Pers.: Fr.) Quél.; Regione Lazio; Novembre 2019; Foto di Felice Di Palma. Spore (7,51)7,53-7,71-8,30(8,48) × (2,70)2,74-3,135-3,52(3,67). Cistidi del filo lamellare. -

2019.11 - Lazio - Tutor Tomaso Lezzi
Felice Di Palma ha risposto alla discussione di Tomaso Lezzi in Funghi Trovati Anno 2019
Agaricus augustus Fr.; Regione Lazio; Novembre 2019; Foto di Felice Di Palma. Spore (6,31)6,39-6,75-7,16(7,18) × (4,55)4,68-5,06-5,47(5,51). Cistidi del filo lamellare. -

2019.11 - Lazio - Tutor Tomaso Lezzi
Felice Di Palma ha risposto alla discussione di Tomaso Lezzi in Funghi Trovati Anno 2019
-

2019.11 - Lazio - Tutor Tomaso Lezzi
Felice Di Palma ha risposto alla discussione di Tomaso Lezzi in Funghi Trovati Anno 2019
-

2019.11 - Lazio - Tutor Tomaso Lezzi
Felice Di Palma ha risposto alla discussione di Tomaso Lezzi in Funghi Trovati Anno 2019
Saproamanita vittadinii (Moretti) Redhead, Vizzini, Drehmel & Contu; Regione Lazio; Novembre 2019; Foto Felice Di Palma. Spore (10,23)10,44-11,07-12,42(12,64) × (8,02)8,06-8,155-9,28(9,56). Imenio e basidi. -

2019.10 - Campania - Tutor Felice Di Palma
Felice Di Palma ha postato un topic nell'area Funghi Trovati Anno 2019
-

2019.03 - Lazio - Tutor Tomaso Lezzi
Felice Di Palma ha risposto alla discussione di Tomaso Lezzi in Funghi Trovati Anno 2019
-

2019.03 - Lazio - Tutor Tomaso Lezzi
Felice Di Palma ha risposto alla discussione di Tomaso Lezzi in Funghi Trovati Anno 2019
-

2019.03 - Lazio - Tutor Tomaso Lezzi
Felice Di Palma ha risposto alla discussione di Tomaso Lezzi in Funghi Trovati Anno 2019
-

2019.03 - Lazio - Tutor Tomaso Lezzi
Felice Di Palma ha risposto alla discussione di Tomaso Lezzi in Funghi Trovati Anno 2019
Cyclocybe cylindracea (DC.) Vizzini & Angelini; Regione Lazio; Marzo 2019; Foto di Felice Di Palma. Su tronco tagliato di Acero, in pieno centro cittadino. -

2018.10 - Campania - Tutor Felice Di Palma
Felice Di Palma ha postato un topic nell'area Funghi Trovati Anno 2018
Felix. -

Ophrys incubacea Bianca
Felice Di Palma ha risposto alla discussione di Felice Di Palma in Orchidee Lazio Anno 2018
Grazie ragazzi ;) Felix. -
-

Ophrys tenthredinifera subsp. neglecta (Parl.) E.G. Camus
Felice Di Palma ha postato un topic nell'area Orchidee Lazio Anno 2018
Ophrys tenthredinifera subsp. neglecta (Parl.) E.G. Camus; Regione Lazio; Aprile 2018; Foto Felice Di Palma. -

Ophrys argentaria Devillers-Tersch. & Devillers
Felice Di Palma ha postato un topic nell'area Orchidee Lazio Anno 2018
Ophrys argentaria Devillers-Tersch. & Devillers; Regione Lazio, via Appia Antica; Aprile 2018; Foto Felice Di Palma. La solita grande variabilità. -

2017.11 - Lazio - Tutor Tomaso Lezzi
Felice Di Palma ha risposto alla discussione di Tomaso Lezzi in Funghi Trovati Anno 2017
-

2017.11 - Lazio - Tutor Tomaso Lezzi
Felice Di Palma ha risposto alla discussione di Tomaso Lezzi in Funghi Trovati Anno 2017
-

2017.11 - Lazio - Tutor Tomaso Lezzi
Felice Di Palma ha risposto alla discussione di Tomaso Lezzi in Funghi Trovati Anno 2017
-

2017.11 - Lazio - Tutor Tomaso Lezzi
Felice Di Palma ha risposto alla discussione di Tomaso Lezzi in Funghi Trovati Anno 2017
-

2017.11 - Lazio - Tutor Tomaso Lezzi
Felice Di Palma ha risposto alla discussione di Tomaso Lezzi in Funghi Trovati Anno 2017
-

2017.12 - Campania - Tutor Felice Di Palma
Felice Di Palma ha postato un topic nell'area Funghi Trovati Anno 2017
Felix.